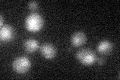
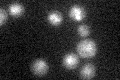

View description
Subunit of both RNase MRP, which cleaves pre-rRNA, and nuclear RNase P, which cleaves tRNA precursors to generate mature 5' ends; binds to the RPR1 RNA subunit in RNase P
Localization:
Intensity:
Fold change:
Significance:
-
C’ GFP library in SD

nucleus24.03 -
N' NOP1pr-GFP in SD

nucleus38.4039 -
N' TEF2pr-mCherry in SD

nucleus8.10011 -
N' NATIVEpr-GFP in SD

nucleus26.5618 -
N' TEF2pr-VC and Cyto-VN in SD

#N/A0 -
C’ GFP library in SD+DTT

nucleus24.921.03No -
C’ GFP library in SD+H2O2
nucleus22.440.93No -
C’ GFP library in Starvation Media
nucleus24.261No -
C’ GFP library on the background of Pup2-DaMP

nucleus -
C’ GFP library on the background of CCT mutant

nucleus30.37011.26333No
